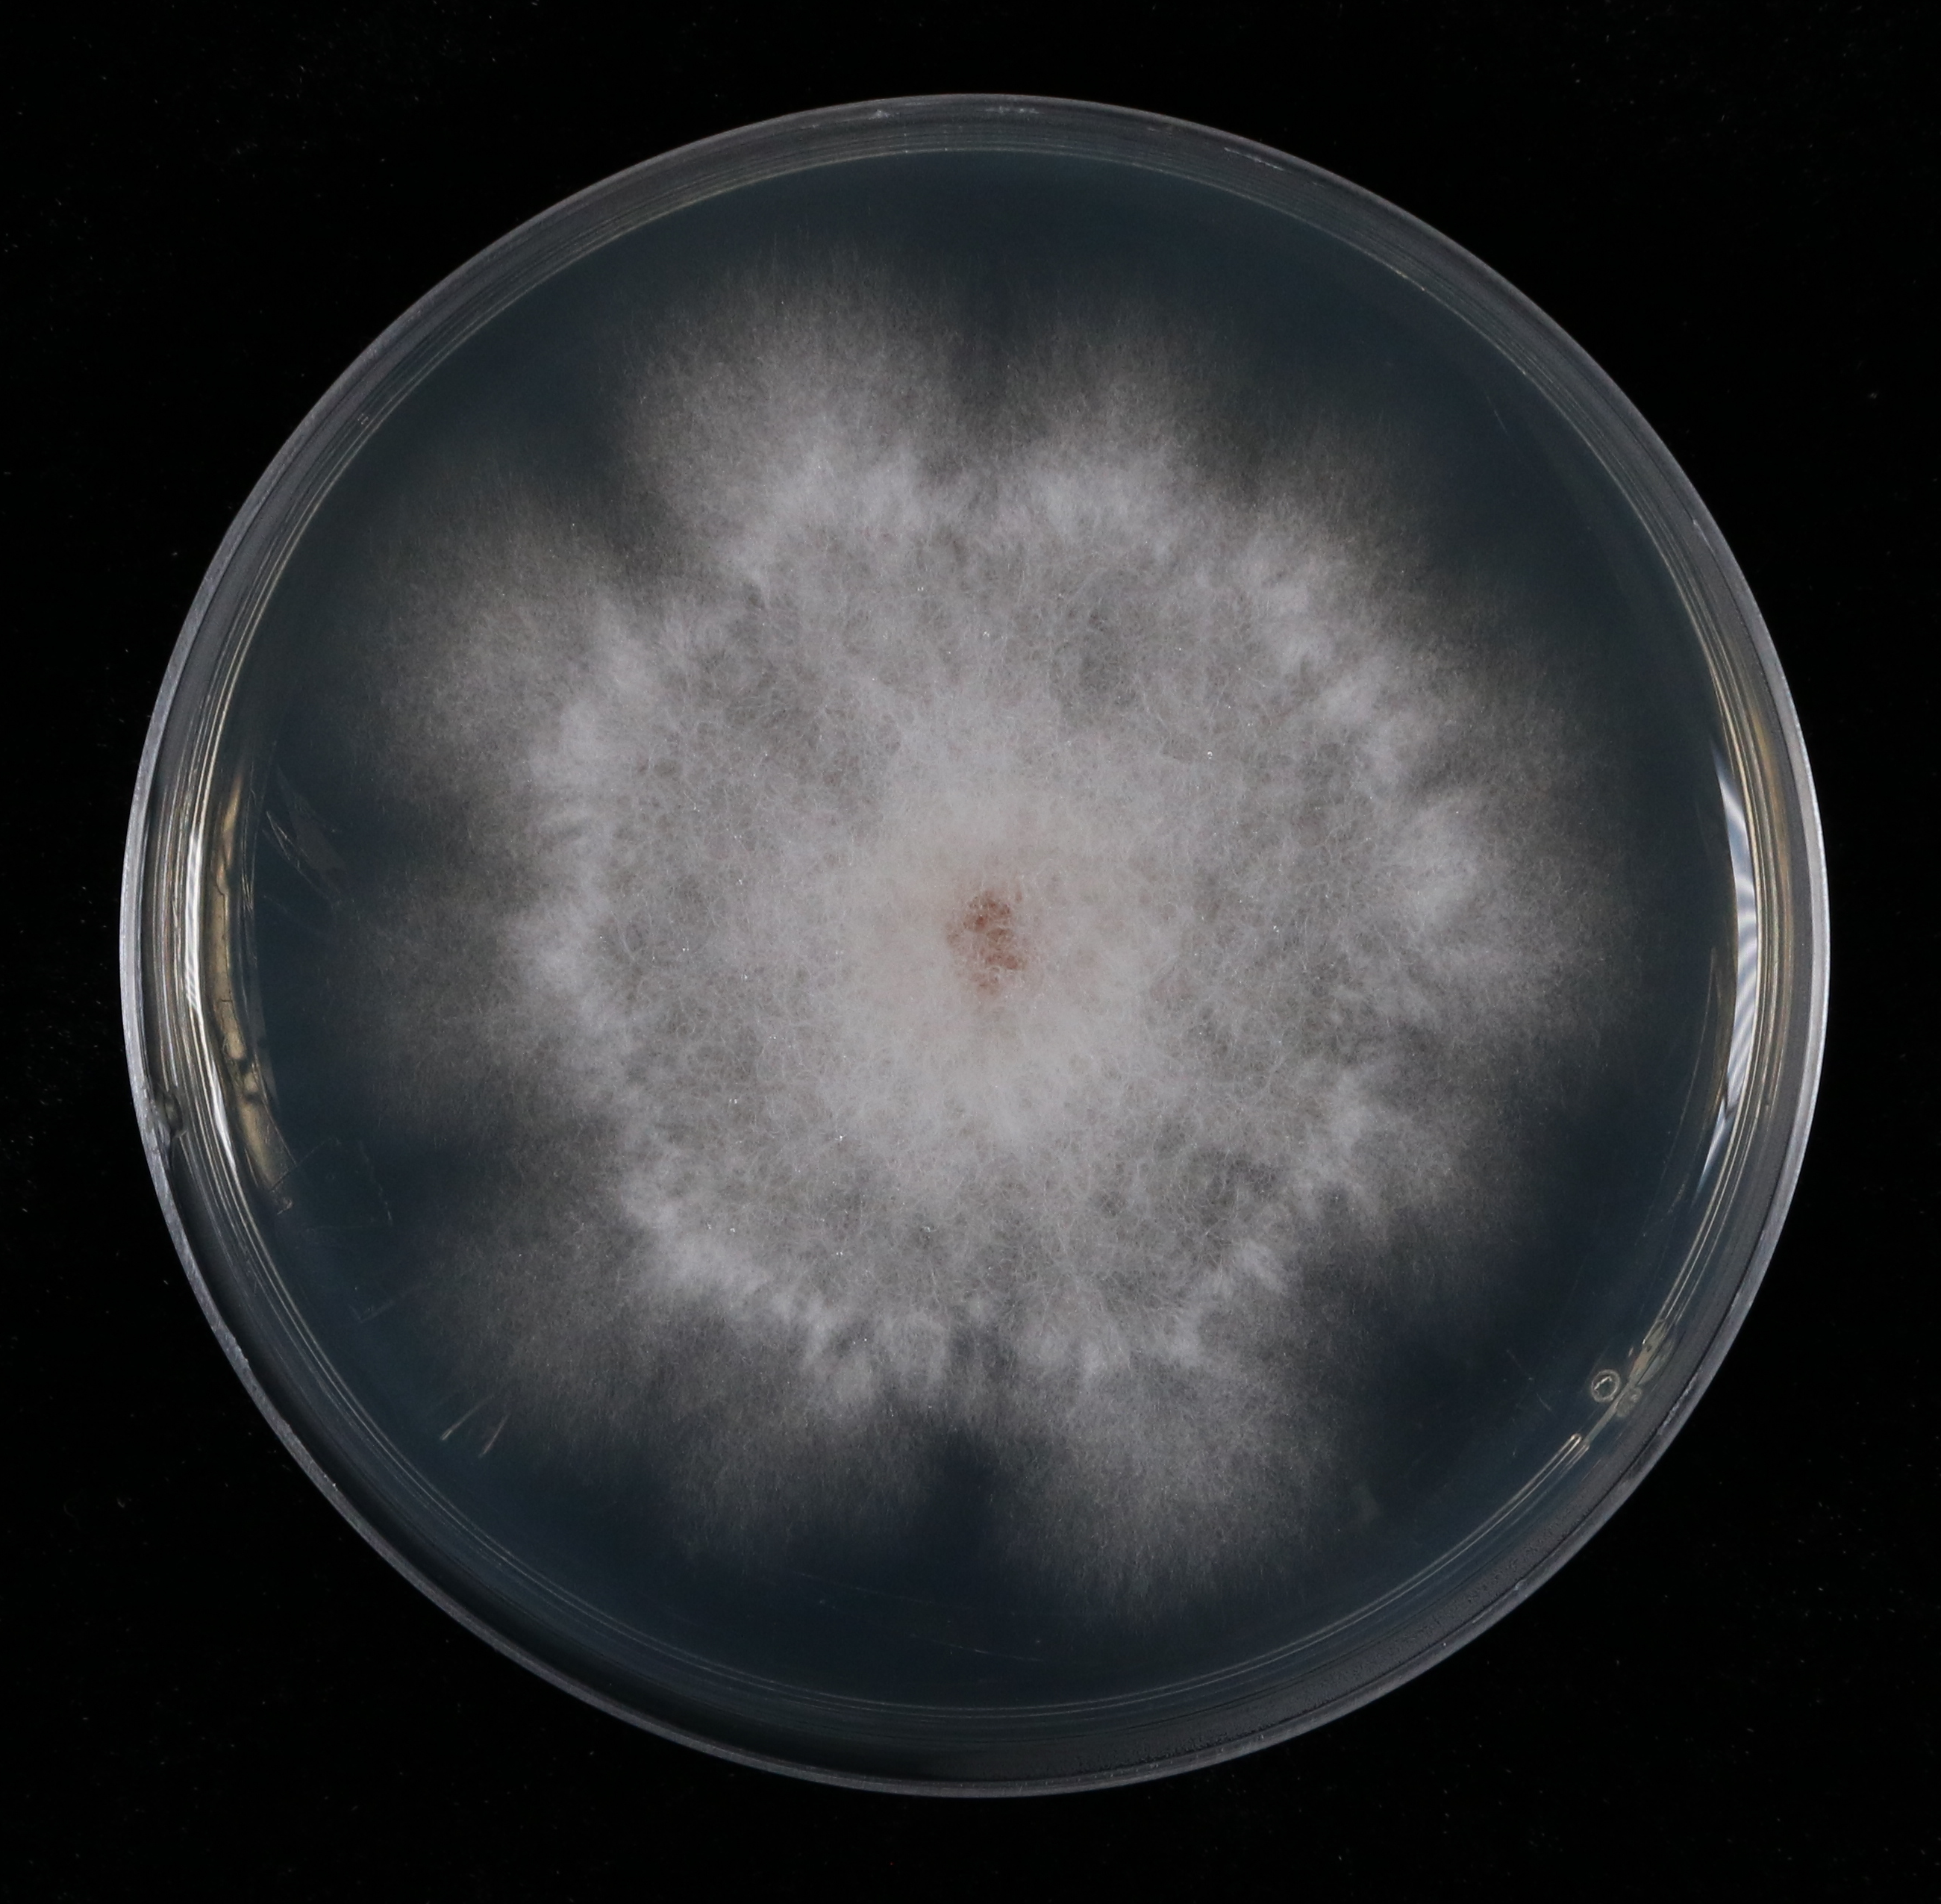
木贼镰孢菌
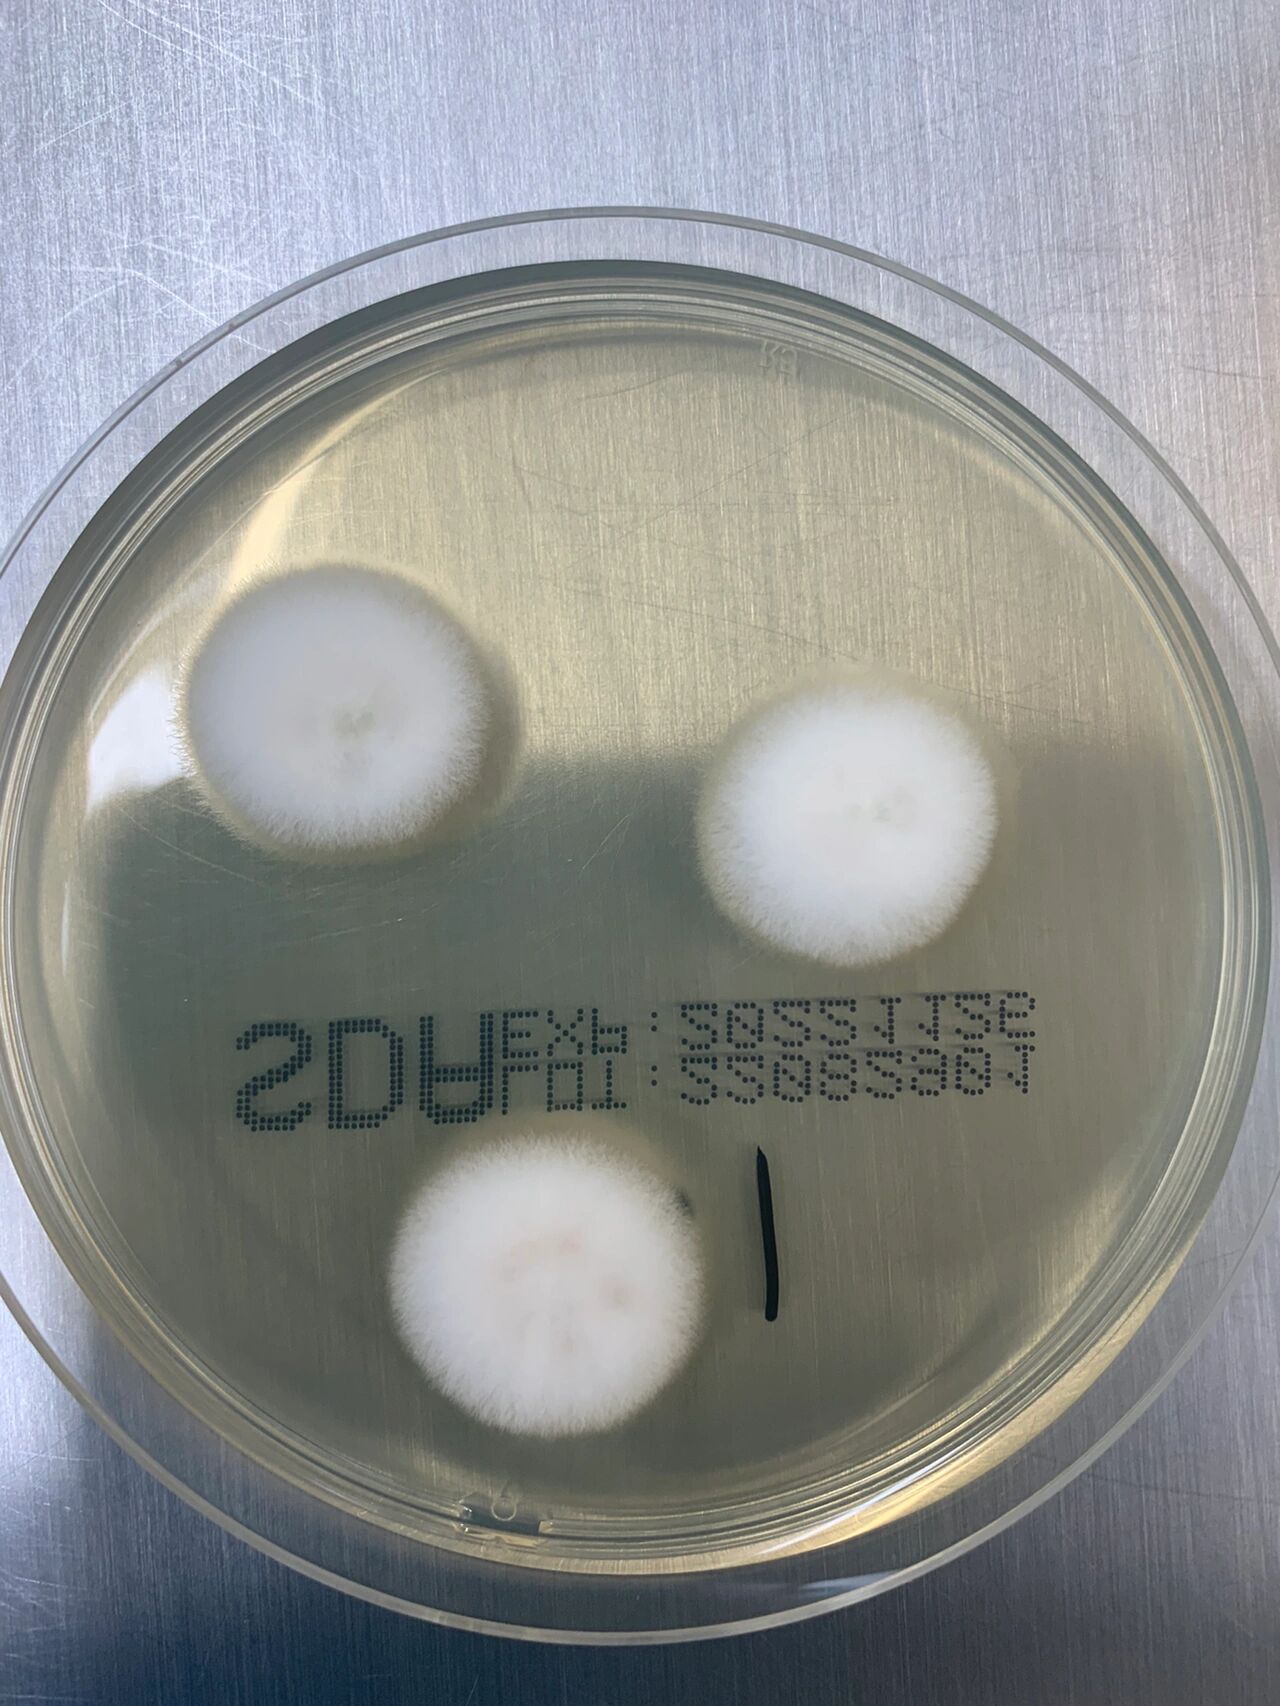
一例丝状真菌(镰刀菌) 镰刀菌菌属又称镰孢霉,该菌存活能力极强可以在

镰孢属图片
镰孢霉属
图片尺寸878x621镰孢属(花之春)
图片尺寸1200x775长直喙镰孢
图片尺寸428x266
镰孢属shbcc d19344
图片尺寸800x800
禾谷镰孢(fusahum graminearum sehw) 子囊菌亚门 镰孢属
图片尺寸750x1000木贼镰孢菌
图片尺寸2601x2551菜豆镰孢
图片尺寸600x756禾草镰孢枯萎病
图片尺寸2592x1944
泡木贼镰孢(植物)
图片尺寸600x403
在野外生长的是寻常镰孢菌图片
图片尺寸612x406
一例丝状真菌(镰刀菌) 镰刀菌菌属又称镰孢霉,该菌存活能力极强可以在
图片尺寸1280x1706
尖镰孢菌(斜面)
图片尺寸365x232镰孢刺皮耳
图片尺寸1504x1452
湖北省蔬菜根际土壤中的镰孢菌分布特征
图片尺寸403x259蚀脉镰孢
图片尺寸554x381腐皮镰孢
图片尺寸600x800尖镰孢
图片尺寸600x800
镰胞菌菌丝体(1600x拍摄).
图片尺寸800x600节镰孢桃生变种
图片尺寸505x414
因为饲料管理不当,镰孢菌感染率激增,母猪的假孕率也水涨船高.
图片尺寸720x483